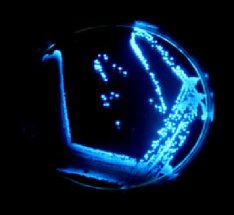

الدارات البكتيرية
الدارات البكتيرية
مقدمة
تمكن الباحثون من تصميم أداة قادرة على التحسس لأي شيء تقريبا وذلك عن طريق تفاعل البكتريا مع رقائق سيليكونية ؛ و كطائر الكناري؛ تستطيع الميكروبات إدراك الأخطار البيئية قبل أن يستطيع الإنسان ذلك. من السهل رؤية رد فعل الكناري ، لكن كيف يمكن لك أن تصف ما هو إحساس الميكروب؟! وكيف تستطيع أن تقنع الميكروب بالتواصل معك؟؟ هناك طريقة واحدة لذلك ... بتفاعل الميكروب مع رقاقة السيليكون!
حيث استطاع الميكروبولوجي "غاري سايلر" وزملاؤه من جامعة تينيسي من تطوير أداة تستخدم الرقائق لجمع الإشارات من مبدل بكتيريا خاص، قام الباحثون باستخدام هذه الأدوات المعروفة باسم ( Bioluminescent Bioreporter Integrated Circuits) أو الدارات المتكاملة المصدرة للضوء حيويا واختصارا تدعى بـ "BBIC" لتتقفى أثر التلوث على الأرض، ومؤخرا، وبدعم من مكتب ناسا للأبحاث الفيزيائية والبيولوجية، قام الباحثون بتصميم نسخة معدلة من هذه الرقاقة خاصة بالسفن الفضائية.
فريق العمل
قام فريق “سايلر” المتكون من مجموعة من الباحثين في جامعة تينسي، وهم: ستيف ريب، سيد إسلام وبين بلالوك. وكذلك المتعاونين في JPL (مجموعة “سايلر” ) ومركز كينيدي الفضائي. بهندسة الميكروبات حيويا بحيث تشع باللون الأزرق المخضر لدى وجود مواد ملوثة ، بعدها قاموا بضم هذه الميكروبات أو البكتيريا إلى رقاقة خاصة مصممة لقياس الضوء تدعى Microlumino meters أو مقياس التألق الميكروبي .
ما الذي تقوم به الـ "BBIC" ؟؟
يرى "سايلر" أنها طريقة قليلة الكلفة ومنخفضة في استهلاك الطاقة للكشف عن الملوثات وهي أدوات بالغة الصغر ..حيث أن كل دراة متكاملة من نوع "BBIC" ذات أبعاد 2*2 ميلي متر تقريبا. وحجم الأداة كاملة مع مصدر الطاقة الخاص بها بحجم علبة الثقاب تقريبا. وبحيث يقوم الفريق بمراقبة بيئة الميكروبات باستمرار...
تهتم وكالة الفضاء الأمريكية "NASA" بالكشف عن التلوث، لأن سفن الفضاء محكمة الإغلاق ولا مجال لتهويتها. وبذلك تتراكم الغازات المتصاعدة من التجارب العلمية و السموم الناتجة عن العفونة، ما قد يشكل خطرا على حياة الرواد.
إن الدارات البكتيرية BBIC”s يمكن ان تصنع بحيث تكون قادرة على التحسس لأي نوع من أنواع الملوثات، مثل: الأمونيا، الكادميوم، الكروم، الكوبالت، النحاس، البروتينات، الزئبق، الأمواج فوق الصوتية،الأشعة فوق البنفسجية، الزنك أو الخارصين والكثير غيرها !!
إن هذه الدارات متينة بشكل مذهل. حيث الميكروبات تنمو بقوة في العديد من البيئات ، ولذلك فإنه بالإمكان تصميم دارات قادرة على مجاراة كل الظروف المختلفة.
يقول غاري “سايلر”:" يمكن لهذه الدارات أن تزيل التلوث من أي شيء حتى لو كان خزان وقود طائرة نفاثة !".
يمكن للميكروبات أن تحمي نفسها من السموم، إلا أنها تحتاج إلى العديد من مقومات الحياة كالغذاء ( مازالت كائنا حيا ) يقول “سايلر” : " إن تأمين احتاجاتها اللازمة للحياة جزء أساسي من عملنا ! ".
إلا أنها ليست المشكلة الوحيدة، حيث أن الميكروبات المكونة للدارات يجب أن تكون ثابتة ضمن أبعاد الدارة. يقول سايلر: " يكمن التحدي الأكبر في منع الميكروبات من الحركة، بطريقة تسمح لها بالحياة لأطول فترة ممكنة ".
يجري الباحثون اختباراتهم على مجموعة من المواد القادرة على حصر الميكروبات ضمن نطاق الدارة وأن تكون المادة المستخدمة شفافة للضوء; ما يسمح للميكروبات أن تضيئ. ومسامية ; حتى تسمح للتلوث بالوصول إلى الميكروبات. وقادرة على حفظ الغذاء لها.
ويضيف “سايلر” ..
" نسعى بشكل أساسي لتوفير الغذاء للعضيات الممنوعة من الحركة دون أن نترك لها مجالا للتكاثر . لا نرغب أن تنمو كثيرا ، والأفضل ألا تنمو أبدا ! لأنها إن نمت ستغير من كمية الخلايا في النظام ، وستغير من كمية الضوء المشع وفقا لكمية الملوثات "
يقول سايلر :
"هناك حاجة لحوالي بضعة ألاف ميكروب لكل رقاقة لتوليد ضوء كاف وهي ليست كثيرة العدد كما يبدو ، فهي كافية فقط لتغطية رأس دبوس"
يأمل “سايلر” في تطوير هُلام يُبقي المكروبات محافظة على وظائفها عدة أشهر، تربط الحساسات بجدران السفينة الفضائية ويتم مراقبة جو السفينة بشكل مستمر. للتأكد من أن المكروبات لا تزال فعالة.
"نحن نقوم بحث الخلايا بشكل كهربائي لتشكيل الضوء ،لذلك يمكننا إعطاء نبضات للنظام لرؤية فيما إذا كانت العضيات لا تزال نشيطة وظائفياً."
بعد ستة أشهر سيتم إرسال إشارة تقول "انتبه ، حان وقت استبدال حساس الجراثيم!!!". سيحضر عندها رائد الفضاء بذور الجراثيم المجففة والمجمدة، ويضيف لها القليل من المرطب ويثبتها في الحساس."
"لايتم فعل أي شيء بعد ذلك حتى يتم إرسال إشارة بانتهاء فعالية البكتيريا وذلك بعد ستة أشهر أخرى " .
إن الدارات المتكاملة البكتيرية "BBICs" مفيدة و لها استخدامات على الأرض أيضاً حيث يمكن لهذه الدارات اكتشاف الفورمالديهايد(غاز عديم اللون ) المشع بواسطة الأثاث الخشبي المضغوط أواكتشاف العفونة حتى المتضمنة منها في الأبنية الفقيرة.
يقول “سايلر” :
"إذا عمل هذا الجهاز كما هو مُخطط له ، فيمكنه أن يظهر كنظام مراقبة رخيص جداً عندها يمكنك شراءه من الصيدلية وتثبيته على جدار غرفتك، وسيخبرك فيما إذا تمت إزالة آثار الغاز السام من البساط أو فيما إذا كنت تملك مشاكل كالعفن الأسود ."
"BBICs " المطوّرة يمكنها أن تقوم باكتشاف أي عملية ارهابية بيولوجية ، مثلما هي وسيلة لاكتشاف ضرر إشعاع الـDNA على روّاد الفضاء ،أو كأداة تشخيصية للأطباء.
مثلا : يتصوّر “سايلر” أن هذه الدارات مفيدة لبرنامج معالجة مرضى السكري.
تكون الـ "BBIC" قابلة للزرع ومجهزَة برقاقة كمحطة إرسال يمكنها مراقبة مستويات جلوكوز الدم وتتصل مع نظام بعيد لتسليم الأنسولين .
مثل هذه الأدوات يمكنها أن تمسح سوائل الجسم بحثا عن بروتين معيّن لأورام بارزة وبكلمات أخرى كنظام مبكر للكشف عن السرطان .